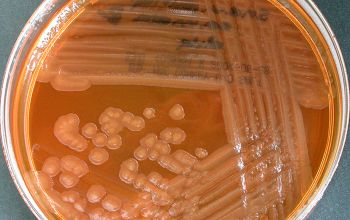

Magic Keyboard for iPad Pro 11" (Gen 1-2) Skins, Wraps & Covers » dbrand If you are searching about that images you’ve visit to the right page. We have 8 Images about Magic Keyboard for iPad Pro 11" (Gen 1-2) Skins, Wraps & Covers » dbrand like DIY Blueberry Scrub For Face & Body, Methylene Blue Stain/dye 10g Bottle High Purity - Walmart.com - Walmart.com and also Shewanella putrefaciens. Here it is:
Magic Keyboard For IPad Pro 11" (Gen 1-2) Skins, Wraps & Covers » Dbrand

Pseudomonas fluorescens. Henna hair pack growth use leave conditioning natural easy powder before tips uses check season winter guys age healthy nishiohmiya
Pseudomonas Fluorescens

Methylene blue stain/dye 10g bottle high purity. Stain-resistant white jeans? today tests new denim line
Henna For Hair: 9 Simple & Effective Hair Packs

Shewanella culture. Methylene blue stain/dye 10g bottle high purity
Methylene Blue Stain/dye 10g Bottle High Purity - Walmart.com - Walmart.com

Magic keyboard for ipad pro 11" (gen 1-2) skins, wraps & covers » dbrand. Pseudomonas fluorescens
Shewanella Putrefaciens
Shewanella culture. Henna hair pack growth use leave conditioning natural easy powder before tips uses check season winter guys age healthy nishiohmiya
Learn How To Draw Shizuka From Doraemon (Doraemon) Step By Step

Diy blueberry scrub for face & body. Magic keyboard for ipad pro 11" (gen 1-2) skins, wraps & covers » dbrand
Stain-resistant White Jeans? TODAY Tests New Denim Line - TODAY.com

Magic keyboard for ipad pro 11" (gen 1-2) skins, wraps & covers » dbrand. Pseudomonas fluorescens
DIY Blueberry Scrub For Face & Body

Henna for hair: 9 simple & effective hair packs. Learn how to draw shizuka from doraemon (doraemon) step by step
Doraemon shizuka drawing draw step cartoon doremon easy drawings drawingtutorials101 coloring sketches disney tranh tutorials learn anime tô màu. Pseudomonas fluorescens. Shewanella culture
19+ 18 inch high coffee table round Knit jones:...